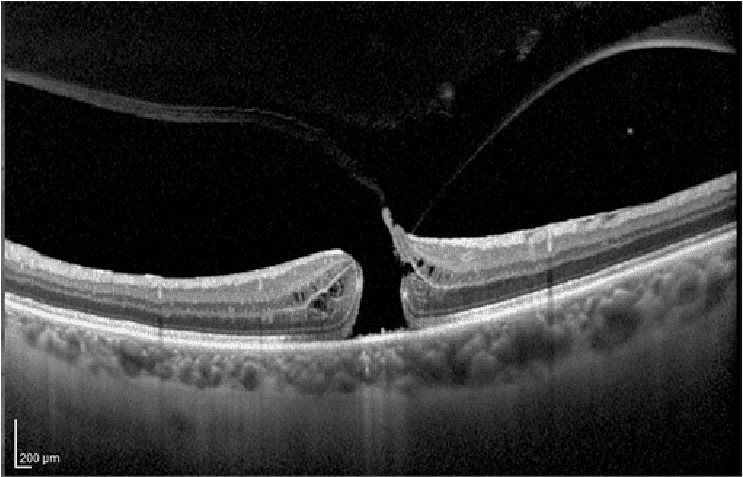
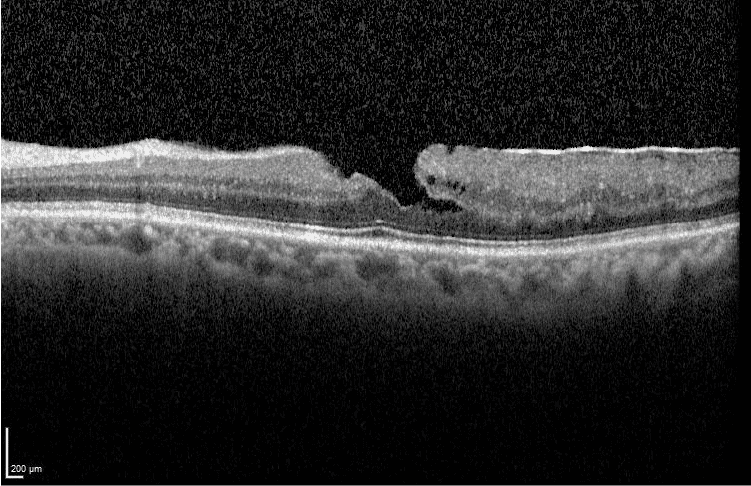

Retina / Agujero Macular
¿Qué es un agujero en la mácula?
Un agujero macular es la apertura de la mácula, que es la parte de la retina responsable de la visión con detalle del ojo. Conforme envejecemos el humor vítreo se despega de la superficie de la mácula de manera normal. Esta descomposición de su estructura molecular está formada por ácido hialurónico, colágeno y agua fundamentalmente. Cuando se produce la separación del gel vítreo de las paredes internas del globo ocular es lo que llamamos desprendimiento de vítreo posterior y se caracteriza por manchas flotantes o "moscas volantes" en el campo visual.
Sin embargo, cuando lo hace de manera brusca y agresiva, puede estirar el techo de la mácula formando un agujero. Ocasionalmente puede llegar a afectar ambos ojos.
Los agujeros maculares pueden clasificarse en función de si afectan total (agujeros maculares completos) o parcialmente el espesor de la retina (agujeros maculares lamelares). Es más frecuente en el caso de mujeres.

Agujero macular completo
Tipos de agujeros maculares
Agujeros maculares completos
Afectan a todas las capas de la retina e implican una mayor pérdida de visión.
Agujeros maculares lamelares
Las capas de la retina están más afectadas que la visión. Pueden estar relacionados con membranas epirretinianas.
Agujero macular completo
Agujero macular lamelar
Causas del agujero macular
Cuando se produce una tracción del vítreo (líquido gelatinoso en el interior del globo ocular), se contrae y tira el centro de la retina hacia delante aparece el agujero macular. Una vez que esto ocurre es muy difícil que se cierre de forma espontánea.
Las causas más comunes de un agujero macular son:

→ Idiopáticas
Aparecen en pacientes sanos sin evidencia de otra enfermedad ocular. Suele estar relacionado con la edad ya que puede aparecer a partir de los 55 años.
→ Miópicas
Suele aparecer en pacientes con miopía alta o patológica (más de 6 dioptrías). Como consecuencia de la estructura anatómica del ojo miope existe un mayor riesgo de agujero macular. Puede llegar a producir un desprendimiento de retina.
→ Traumatismos oculares
Pueden ser producidos por un golpe o por alguna contusión de un objeto, pero también pueden estar causados por algún objeto perforante, así como por el contacto de un producto químico. Como consecuencia, se puede producir un desgarro o rotura en la zona periférica de la retina o un agujero en la zona central o mácula.
→ Inflamación de la mácula
El agujero macular también puede aparecer cuando estamos ante casos de edemas maculares quísticos crónicos secundarios y existe inflamación ocular o alteraciones vasculares de la retina que provoquen oclusiones oculares.
→ Por cirugías intraoculares previas
→ Pacientes que han tenido agujeros maculares en otro ojo
(El 10%-15% de los casos).
Síntomas de un agujero macular
Aunque en sus estadios más iniciales se puede producir una leve visión borrosa aunque, si progresa, pueden aparecer zonas oscuras de visión o escotomas. También se puede producir una visión distorsionada (metamorfopsia). En las fases más severas, el paciente puede detectar una falta de visión central.
En general, los síntomas de agujero macular ocurren solo en un ojo, por lo que es raro que sea bilateral.
Algunos de los síntomas que podemos detectar son:
● En las primeras fases se puede observar una lesión de color amarillenta en la fóvea, que es la parte de la retina en el centro de la mácula y encargada de la visión de detalle, como por ejemplo, para la lectura.
● Cuando el agujero se consolida, éste se detecta en la fóvea.
● Notamos una visión distorsionada como se mira a través de una niebla espesa o de un vidrio ondulado. Nos cuesta diferenciar algunos detalles finos al mirar a algo desde cualquier distancia. Vemos una mancha oscura o punto ciego en el centro del campo de visión.
Factores de riesgo de un agujero macular
¿Cómo prevenir un agujero macular?
Aunque puede suceder a cualquier persona, los pacientes con una miopía de más de 6 dioptrías o los que han recibido un traumatismo ocular severo tienen mayor predisposición a padecer un agujero macular.
Una revisión o control oftalmológico anual es muy importante para detectar precozmente cualquier lesión en la retina o fondo de ojo que de otra forma pueda pasar desapercibida.
Diagnóstico del agujero macular
Para valorar el mayor o menor grado de afectación de un agujero macular el oftalmólogo especialista realizará un completo examen oftalmológico del fondo de ojo.
Es imprescindible la realización de tomografía de coherencia óptica (OCT) de alta resolución con protocolos de escaneado macular individualizados para cada caso y la interpretación por un especialista en diagnóstico por imagen de la mácula.
No obstante, cuando se observa un agujero macular también es necesario valorar el estado de la catarata del paciente para diagnosticar una posible cirugía combinada con extracción de la catarata y cirugía del agujero macular en una misma intervención.
El examen oftalmológico que debe realizarse desde la consulta de un especialista en retina es:
→ Examen pupilar, refraccción y visión lejana y cercana.
→ Estudio de la córnea y cámara anterior para descartar inflamación ocular.
→ Tensión ocular: se mide la presión intraocular del ojo.
→ Tomografía de Coherencia Óptica u OCT Macular: con esta prueba determinamos el tamaño y la forma del agujero macular para observar el estado de las diferentes capas de la retina y descartar edema macular quístico.
→ Angiografía con fluoresceína.
→ Tomografia de coherencia óptica OCT de agujero macular completo.

Tratamiento de un agujero macular
El tratamiento del agujero macular siempre es quirúrgico. Esta cirugía se realiza mediante la técnica de la vitrectomía en la que se eliminará la parte más superficial de la mácula con gran meticulosidad.
El pronóstico final de la visión depende en gran medida de la habilidad del cirujano, además de otros factores como el tiempo de evolución y el tamaño del agujero macular.
Actualmente, un agujero macular también puede tratarse con inyecciones intravítreas que pueden cerrar el agujero y evitar la tracción del vítreo sin necesidad de una operación.

Operación del agujero macular
La cirugía por vitrectomía se realiza con anestesia local y el paciente se vuelve a casa el mismo día de la intervención.
Con este tipo de operación conseguimos eliminar la capa más interna de la retina (membrana limitante interna) para favorecer el relajamiento de la retina y que los labios del agujero macular puedan volver a colocarse sobre el epitelio pigmentario.
Posteriormente se llena el ojo con gas para mantener la presión sobre la retina y que el agujero macular se cierre.
Postoperatorio del agujero macular
Se recomienda que el paciente recién operado de agujero macular mantenga la cabeza hacia abajo durante una semana aproximadamente para que el gas contacte con el agujero macular y así ayude a cerrarlo.
Mientras esto sucede, está prohibido subir a un avión, ya que el gas podría expandirse y subir su presión.
Como seguimiento, durante el postoperatprio se realiza de nuevo otra prueba por Tomografía de Coherencia Óptica (OCT) para confirmar el cierre del agujero macular.
 Cambiar idioma
Cambiar idioma Inglés
Inglés Catalán
Catalán

